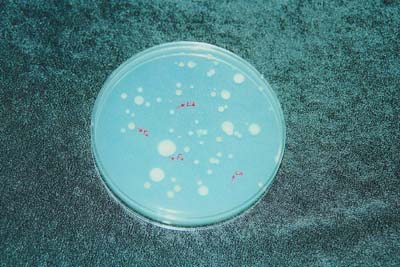

Food safety has always been a main concern and its origins can be traced back to very early times. The Codex Alimentarius provides an attempt to ensure safe food for everyone and has had worldwide impact. It was developed by FAO and WHO in 1962, after a long preparatory phase. The guidelines and standards set by the regulatory body of the Codex Alimentarius have become widely accepted. They have been adopted or taken as a point of reference by most countries (Appendix 1). This is because ensuring food safety is based on the principle of sound science and its proper application. This applies also to fruits and vegetables.
In January 1997, the President of the United States announced The Food Safety Initiative. This promoted a series of measures to be undertaken by American regulatory bodies. During the same year, the "Initiative to Ensure the Safety of Imported and Domestic Fruits and Vegetables" was published. Within this initiative, a series of recommendations or guidelines were put forward which led to the development of Good Agricultural Practices (GAPs) or Good Manufacturing Practices (GMPs). The overall objective was to ensure that fruits or vegetables for consumption, either of domestic or foreign origin, must meet the highest quality and safety standards. Although not mandatory, their aim was to reduce microbiological risks by preventing food contamination and to improve the efficacy of control measures if contamination occurs. Different countries worldwide use these guidelines to develop their own GAPs and GMPs (Appendix 1).
Products go through different stages of operations after harvest. This provides many opportunities for contamination besides those which naturally occur in the field. Consumers strongly reject foreign materials on products or inside packages. These include for, example, dirt, animal feces, grease or lubricating oils, human hairs, insects, plant debris, etc. However, because this is usually due to insufficient care in handling, they are relatively easy to detect and to eliminate. Amore serious problem is the presence of human pathogens on produce. These may not be visible or detected because of changes in appearance, flavor, colour or other external characteristics. It has been shown that specific pathogens are able to survive on produce sufficiently long to constitute a threat. In fact, many cases of illness related to consumption of produce have been reported (Table 12).
Three types of organisms can be transported on fruits and vegetables, which may constitute a risk to human health: virus (hepatitis A, for example), bacteria (Salmonella spp., Escherichia coli, Shigella spp., and others) and parasites (Giardia spp., for example). Mycotoxins and fungi do not usually constitute a problem. This is because fungi development is usually detected and eliminated well before the formation of mycotoxins. In most cases, bacteria is responsible for illnesses related to the consumption of fruits and vegetables.
Produce can become contaminated through mechanisms that are complex (Figure 61). The best strategy to obtain a safe product is to prevent contamination at various points throughout the production and distribution chain. This includes undertaking certain sanitary treatments and maintaining produce under conditions (mainly temperature) which do not favour the development of micro-organisms. This approach is known as the "systems approach" (Bracket, 1998). Every step of the process is a part of an integrated system. Records and/or documentation of all activities and treatments are required so that a tracing scheme is established. In this way, it is possible to identify areas of weaknesses within the system and to take corrective measures. Following strict written procedures for good agricultural practices (GAP) and/or good manufacturing practices (GMP) (Appendix 1) are critical factors for the implementation of such a system. This should be combined with such systems as Hazard Analysis Critical Control Point (HACCP) analysis in order to identify the critical points at which known safety food hazards must be controlled.
This section briefly describes critical factors where risk of microbiological contamination in the production and distribution of fruits and vegetables can affect health and safety. In addition to this, some preventive measures are proposed. These include issues to consider when writing specific GAP and GMP manuals for each crop and growing region.
Some human pathogens are naturally present in the environment. However, fecal deposits(human, animal, or wild animals) are the main source of contamination of produce. Entry is mainly through irrigation or washing water. Microorganisms in surface water (rivers, lakes, etc.) may come from upstream dumping of untreated municipal wastes. Underground water may also be contaminated from septic tanks leaching through soil into aquifers. If only contaminated water is available, underground drip irrigation is the only irrigation system recommended to avoid contamination of above-ground edible plants (Table 13).
Table 12: Isolated pathogens in fruits and vegetables and reported illnesses.
|
Aeromonas spp. |
Alfalfa sprouts, asparagus, broccoli, cauliflower, lettuce, pepper |
|
Bacillus cereus |
Sprouts |
|
Escherichia coli O157:H7 |
Cabbage, celery, cilantro, lettuce(*), pineapple, apple cider(*), alfalfa sprouts(*) |
|
Listeria monocytogenes |
Bean sprouts, cabbage, cucumber, shredded cabbage(*), potato, radish, mushrooms(*), salads(*), tomatoes and other vegetables |
|
Salmonella spp. |
Artichoke, bean sprouts(*), tomato(*), alfalfa sprouts(*), apple cider(*), cauliflower, celery, eggplant, Belgian endives, pepper, cantaloupe(*), watermelon(*), lettuce, radish and several vegetables |
|
Clostridium botulinum |
Shredded cabbage(*) |
|
Shigella spp. |
Parsley, leafy vegetables, shredded lettuce(*) |
|
Cryptosporidium spp. |
Apple cider(*) |
|
Cyclospora spp. |
Raspberry(*), basil(*), lettuce(*) |
|
Hepatitis A |
Lettuce(*), strawberry(*), frozen strawberry(*) |
(*) Reported illnesses. Adapted from Brackett (1998) and Harris (1998).

Figure 61: Mechanisms by which fruit and vegetable can become contaminated with pathogenic microorganisms. (Adapted from Harris, 1998).
The main causes of contamination include: animal manure or sewage waste used as organic fertilizers or the presence of animals in production areas. Manure should be composted aerobically to reach 60-80 °C for a minimum of 15 days. Composting of static piles and earthworms do not guarantee that microorganisms have been inactivated. Wastewater and municipal wastes should only be used if effective disinfecting systems are available.
Table 13: Potential risks of microbial contamination and recommended preventive measures.
|
Production step |
Risks |
Prevention |
|
Production field |
Animal fecal contamination |
Avoid animal access, either wild, production or even pets. |
|
Fertilizing |
Pathogens in organic fertilizers |
Use inorganic fertilizers. |
|
Irrigation |
Pathogens in water |
Underground drip irrigation |
|
Check microorganisms in water |
||
|
Harvest |
Fecal contamination |
Personal hygiene. Portable bathrooms. |
|
Risk awareness |
||
|
Pathogens in containers and tools |
Use plastic bins. Cleaning and disinfecting tools and containes. |
|
|
Packhouse |
Fecal contamination |
Personal hygiene. Sanitary facilities. Avoid animal entrance. Eliminate places may harbor rodents. |
|
Contaminated water |
Alternative methods for precooling. Use potable water. Filtration and chlorination of recirculated water. Multiple washing |
|
|
Storage and transportation |
Development of microorganisms on produce |
Adequate temperature and relative humidity. Watch conditions inside packaging. Cleaning and disinfection of facilities. Avoid repackaging. Personal hygiene. Do not store or transport with other fresh products. Use new packing materials |
|
Sale |
Product contamination |
Personal hygiene. Avoid animal access. |
|
Sell whole units. Cleaning and disinfection of facilities. Discard garbage daily. |
The production and harvest of fruits and vegetables tend to rely heavily on human labor. Other sources of contamination include the hygiene conditions of field workers. First, production fields are usually a long distance from bathrooms, together with other sanitary facilities for the hygiene of personnel, Second, hired teams of migrant labour temporarily live in the fields. Here, conditions and sanitary practices are considered unacceptable. In addition to providing portable toilets, staff need to understand the importance of proper hygiene practices for food safety.
The type of product also has an influence: in vegetables which are characterized by low acidity in tissues, bacteria tends to dominate, while fruits are mainly colonized by fungi. Crops growing close to the ground like strawberry and leafy vegetables in general, are more susceptible to contamination by water, soil, or animals when compared to tree crops. Finally, some chemical constituents of tissues such as organic acids, essential oils, pigments, phytoalexins etc, have antagonistic effects and provide some form of protection against the development of micro-organisms.
As with other handling operations, numerous opportunities exist for contamination during harvest. Wounds and bruises may exude latex and other plant liquids from tissues and provide the substrate for the growth of microorganisms transmitted by hands, tools, clothes, water, or containers. Contamination at any point throughout the distribution chain can be exacerbated by the conditions to which the produce is exposed. Temperature is the most important factor to be considered.
The issues highlighted in previous paragraphs on product handling and personal hygiene are equally valid for preparation of the product for market. However, some additional factors need to be taken into account.
In packinghouses or processing plants, people who are ill or have open wounds should be forbidden from making contact with the product. Workers should use hairnets and clean outfits when handling the product.
Street clothes must be left outside the working area and eating or drinking in the pack-house should be forbidden. Workers should wash their hands daily at the beginning of operations and every time they return to work, particularly after having used restrooms.
However, the main source of contamination in terms of product preparation for market, is probably water. Water is essential for packinghouse operations either for washing the product, containers, and facilities or for dumping, hydrocooling. Other uses include personal hygiene or as a medium for waxes, chemicals, etc.
4.2.2.1 Water Disinfection
Water impurities are frequently concerned with: the suspension of materials, microorganisms, organic matter, off-colour, off-odor as well as minerals and dissolved gases. Municipal water is filtered and treated (normally with low chlorine concentrations) to ensure that it meets the chemical and microbiological requirements for food safety and contact with food. Alternative sources of water must be filtered and sanitized.
Sanitation is necessary to avoid the spread and contamination to other units, even with the use of municipal water. Different methods exist for water disinfection. These include chemical, thermal, ultrasonic waves or irradiation. In postharvest operations, chlorine and its derivatives are the cheapest and most widely used substances to destroy bacteria and fungi in water as well as on the surface of fruits.
Chlorine is a gas with a strong and penetrating odor and is extremely reactive chemically. At post harvest level, it is used mainly in three different forms: as pressurized gas from metal cylinders, as calcium hypochlorite (solid) or liquid as sodium hypochlorite, commonly known as "bleach" for household whitening and sanitizing. Chlorine gas is difficult and dangerous to handle and is normally limited to large operations such as municipal water treatment. Calcium hypochlorite is widely used in concentrations of 65% but is difficult to dissolve in cold water. Sodium hypochlorite is more expensive than the other two formulations in terms of chlorine concentration (5 to 15%). However, its easy dosage makes it convenient for small size operations.
In aqueous solution, chlorine exists as hypochlorous acid, hypochlorite ion, or as a variation of both, depending on the pH solution: the former predominates in acidic solutions while the latter in alkaline solutions. Germicidal action of hypochlorous acid is about 50-80 times higher than hypochlorite. In order to maximize the effect on microorganisms, the pH solution should have a range of between 6.5 and 7.5. Below this range, the hypochlorous form is extremely unstable and tends to escape as a gas resulting in irritation and discomfort to workers. It also becomes extremely corrosive for the equipment. On the other hand, its effectiveness as a sanitizer is significantly reduced above 7.5. To keep pH values within permitted ranges, vinegar could be used to acidify while sodium hydroxide could be used to alkalinize. Maintenance kits for swimming pools could be used to monitor pH. Chlorine as a gas lowers the pH of the solution while as hypochlorite, either of calcium or sodium, this will be increased.
Concentration of active chlorine is expressed in parts per million (ppm). Concentrations of active chlorine in the range of 0,2 to 5 ppm are able to kill most bacteria and fungi present in water. However, in commercial operations higher concentrations are used (100-200 ppm) for washing and hydrocooling. Aliter of household bleach (80 g active chlorine/dm3) in 400 liters of water represents about 200 ppm, and in 800 and 1600 liters, about 100 and 50 ppm, respectively. It is convenient to start daily operations with: low concentrations (100-150 ppm); to increase the amount of chlorine in solution as water becomes contaminated with dirt and plant debris and an increase in microorganisms.
Quick exposure (around 3-5 minutes) is adequate for the purposes of disinfection. However, in addition to pH level and impurities, the temperature of the solution is also important. This is because low temperatures can reduce activity. Another important factor is the extent to which microorganisms can be developed. This is because their spores are from 10 to 1000 times more difficult to kill compared to their vegetative state.
The use of chlorine in fruits and vegetables is banned in some countries. This is because it is possible for it to react with organic matter leading to the formation of chlorate compounds and trihalomethans. These are suspected of being carcinogenic. As a result of this, the industry is investigating alternative sources of sanitizers.
Ozone is a gas with a strong oxidizing action in concentrations of 0,5-2 ppm. It has been approved for water sanitation. However, it is difficult to apply. This is because reliable methods for monitoring the level of concentrations do not currently exist. In addition to this, it is only effective within a reduced pH range of (6-8) and must be generated in the same place of application. It is dangerous to humans in concentrations higher than 4 ppm and may cause damage to some plant tissues. In spite of these limitations, it is probably the most promising compound to replace chlorine. Ultraviolet light in wavelengths of 250-275 nm can also be used. It is unaffected by water temperature or pH. However, water must be filtered as turbidity reduces its efficacy.
Water management is also important. This is because several washes are required. This is more effective than a single wash. The following is an outline of a procedure for good cleaning practices: First, undertake an initial wash to eliminate dirt and plant debris. Second, wash with chlorinated water and finally rinse with plain water. Brushing or water agitation increase washing efficiency. Water recirculation should be undertaken in reverse to the flow of the product, i.e. rinsing waters can be reused for the initial washing. Hydro cooling is one of the most efficient systems for precooling. It is, however, also one of the most risky in terms of microbial contamination. This can be caused by water infiltration inside the fruits. As a result of this, it is important to consider alternative precooling methods such as forced air.
4.2.2.2 Plant hygiene.
Industrial facilities follow a system of strict hygiene measures. However, when produce is prepared for the fresh market, limited attention is normally paid to hygiene facilities. This is particularly the case when low cost materials have been used in the construction of the packing shed.
Although other factors need to be taken into account prior to layout and organization, it is important that the packing shed be designed to allow for thorough cleaning procedures. The reception area should be kept separate from the delivery area. Similarly, "clean areas" or areas where product is prepared, should be kept separate from other areas or where product is handled as receivables from the field. There should be a clean area where workers can take breaks, change clothes, and take care of personal hygiene. For example, the availability of hot water, showers, and clean restrooms within a clean and comfortable environment.
While it is a requirement that dust and other impurities are eliminated, liquid sanitizers should be used to disinfect the facility and equipment, particularly those in contact with produce. Chlorine based sanitizers are the most widely used disinfectants. However, the choice depends on type of water, pH, cost and the type of equipment. Iodine based disinfectants (iodophors) are less corrosive to metals than chlorine. They are unaffected by organic matter but their effectiveness within the pH range is quite narrow (2,5-3,5). In addition to this, they may stain surfaces. Quaternary ammonium compounds are widely used for disinfecting floors, walls, and aluminum equipment. While effective over a wide pH range, they are not affected by organic matter and are non-corrosive. However, they are expensive and leave residues on surfaces. There are other sanitizers available on the market that can be used in food plants.
Animals of all types, including mammals, birds, reptiles, and insects can spread microorganisms with their droppings. Their entry into packing areas should be forbidden, including pets. It is necessary to seal crevices and keep doors, windows, and air inlets closed or fitted with insect-proof screens. It is also important to have insect and rodent control programs, together with approved pesticides, traps, and baits. Facilities and the surrounding environment must be kept clean and tidy to prevent the nurturing and harboring of insects, rodents, reptiles and other animals. Garbage and waste materials should be removed daily.
In terms of sanitation, there are two potential sources of risk: contamination by human pathogens and their growth and development due to the favorable conditions created because of the packaging environment or storage area. Factors highlighted earlier about hygiene of personnel and facilities are also applicable here. Two additional recommendations include: the use of new containers and not undertaking repackaging. Other considerations to prevent cross contamination include not storing or transporting fruits and vegetables with other fresh food items.
The best strategy to prevent growth and development of human pathogens is to keep product at recommended storage conditions, particularly temperature. Microorganisms can be divided into three main categories acording to their level of adaptation to temperature. These are: psychrotrophic - the ability to grow under refrigerated conditions, although the optimum ambient temperature is (20-30 °C); b) mesophilic - those that develop best at ambient temperature (20-40 °C) but not under refrigeration and c) ther-mophillic - requiring temperatures above 40 °C. The last two (i.e. b and c) do not concern fruits and vegetables for the fresh market, but may be present in inadequatelt processed items. Generally, refrigeration inhibits growth of microorganisms, but psy-chrotrophics may develop on produce if storage time is too long.
The atmosphere at which a product is stored also influences microbial development. Clostridium botulinum, for example, is not a concern when a product is prepared for the fresh market. However, it may develop and produce toxins on tissues with a pH higher than 4,6 and under conditions of low oxygen. It may be present in inadequately pasteurized canned products but it may also develop under modified atmosphere conditions. It has been reported that this bacterium (Table 12) can cause human poisoning.
Fruits and vegetables may become contaminated at the point of sale, storage, and home preparation. The previous discussions on personal hygiene and prevention of contact with animals are also valid here. The common practice at retail of cutting large fruits into portions (pumpkins, watermelons, melons, etc.) should be avoided and refrigeration is recommended for the most perishable items.
Fruits and vegetables are microbiologically safer compared to meat, milk, poultry, and other foods. However, during the process of fighting organisms they do not usually undergo a kill step so many organisms are not destroyed (by cooking) and are therefore potentially dangerous if contamination exists. It is difficult to estimate how real this potential threat is. This is because it is usually reported when it becomes serious. In addition as fruits and vegetables are regarded as "healthy food", they are not considered to be the cause of food-related illnesses. Instead, other food eaten during the course of the same day is usually to blame. However, available evidence seems to indicate that this is increasingly becoming a problem. The reasons for this may be twofold: First, there is a trend towards environmentally friendly practices in agriculture. The use of manure based organic fertilizers or soil amendments increases the risk of contamination. Second, the concentration of supply particularly through supermarket distribution centers supplying a large number of stores, means that a single case of contamination can have an enormous impact throughout the system.
To obtain high quality produce with minimum risk levels, the first step is to understand the complexity of microbial contamination and recognize its importance. The examples of good agricultural and manufacturing practices described in these paragraphs may not apply to all fruits and vegetables. However, they may be useful to devise specific preventative measures. With the current level of technology, it is not possible to eliminate this risk. However, it is important to know how to minimize it as much as possible. It is cheaper and more effective to prevent microbial contamination of fruits and vegetables than to have to confront the problem when it occurs. Asuccessful food safety program requires serious commitment from everyone throughout the food chain from production to consumption. Key factors to be considered are: the availability of trained personnel, and a system that ensures that there are no missing links in the quality chain as regards contamination prevention.
Many different testing procedures exist for the detection of microorganisms, such as total plate counts (Figure 62) or aerobic plate count. They give an idea of the extent of microbial contamination, but have limited value in terms of assessing food safety. A wide range of microorganisms exist naturally on the surfaces of fruits and vegetables and they will colonize a growing medium. However, this does not mean that they are a health hazard. These types of tests are useful for monitoring the hygiene system or evaluating the impact of certain sanitary measures. Detection of Salmonella spp., fecal coliforms, E. coli, and other pathogens require specific tests and their lack of detection does not mean that the produce is free from other harmful microorganisms. As a result, the best strategy is to minimize the risk and to prevent as much contamination as possible. An important aspect in any program of good agricultural or manufacturing practices is to have a tracing system. This is because it is possible to identify and pinpoint quickly problems of contamination. The necessary corrective measures can be undertaken as soon as possible. The short lead time between harvest and consumption of fruits and vegetables makes it difficult to react in time if an outbreak is detected. In spite of these limitations, keeping records may help to reduce the population at risk and should complement all preventive measures described in this section.
Figure 62: The total plate count of aerobic colonies on a growing media gives an idea of the degree of contamination.